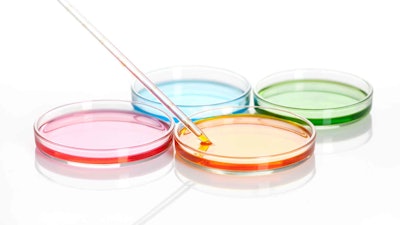
There must be a shift in thinking by regulators within the European Commission to recognize the fact that multifunctional ingredients can play an important role in product preservation.

Editor’s note: This month’s “back to the basics” theme would be incomplete without a discussion on preservation. In the following commentary, industry expert and consultant Steve Schnittger, Ph.D., previously the vice president of global microbiology and fermentation in R&D for the Estée Lauder Cos., shares his thoughts and suggestions about this pain point for formulators and our industry.
Read this article and more in the September 2023 digital magazine.
The global personal care industry is at a crossroads when it comes to product preservation. On one side, consumers and marketing teams at personal care companies are looking for products that contain ingredients identified as being sustainable and green, and that comply with the guidelines outlined for these product types. The ingredients in question include emulsifiers, surfactants and functional ingredients, as well as preservatives.
 On one side, consumers and marketing are looking for products that contain ingredients identified as being sustainable and green.
On one side, consumers and marketing are looking for products that contain ingredients identified as being sustainable and green.
On the other side, the European Commission will only permit those ingredients that are listed on Annex V to be used as preservatives in formulations. The use of any other ingredient that claims to deliver preservative efficacy could result in that product being removed from the marketplace.
In the middle is a growing list of ingredients that have been identified as multifunctional due to their ability to contribute not only preservative efficacy to a formulation, but also antioxidant, moisturizer, humectant, fragrance and solubilizing properties. Since these ingredients are not on Annex V, they cannot be recognized for their preservative efficacy. Therefore, ingredient manufacturers are identifying these ingredients as preservative boosters and potentiators.
When Annex V was first created, a broad list of chemistries such as formaldehyde donors, parabens, halogens, isothiazolinones and organic acids were available for use. Therefore, there had to be a positive list that identified both acceptable levels and areas of application. This level of control was needed to protect the consumer from potential adverse reactions and ensure product safety.
Today, many of these same ingredients have been removed from the marketplace. This is due in part to safety concerns or negative perceptions by consumers driven by reports on the internet that question the safety of these ingredients. This has forced many personal care companies to remove these ingredients from their formulary.
As the use of conventional preservatives continues to decline in the marketplace, and the use of preservative boosters continues to grow, the preservative benefits of these multifunctional ingredients must be recognized by global regulatory authorities. Preservative boosters are capable of reducing the levels of conventional preservatives in a formulation – and their potentiation effect is well-documented, but they also deliver preservative efficacy on their own.
For this reason, in my view, there must be a shift in thinking by regulators within the European Commission to recognize the fact that multifunctional ingredients can play an important role in product preservation. And that the cosmetic chemist should be able to use any resource possible to ensure preservative efficacy. In the meantime, formulators can continue using non-traditional preservatives but they run the risk of being flagged in Europe and Japan.
There must be a shift in thinking by regulators within the European Commission to recognize the fact that multifunctional ingredients can play an important role in product preservation.
There must be a shift in thinking by regulators within the European Commission to recognize the fact that multifunctional ingredients can play an important role in product preservation.
As stated in ISO 11930: Antimicrobial protection is based on a combination of formulation characteristics, production conditions and final packaging. The overall evaluation takes into account the microbiological risk assessment together with the preservation efficacy test results and it is the manufacturer’s responsibility to provide information to demonstrate that safety has been satisfactorily demonstrated and that the level of risk is tolerable.
Furthermore, even if a formula fails the preservative efficacy test but the package type reduces the risk, and the risk analysis demonstrates the existence of strengthened control factors (risk reduction), then the cosmetic product is deemed to meet the requirements of this International Standard.
It is the responsibility of the manufacturer to ensure preservative efficacy and the safety of a formulation based on a thorough toxicological, safety and risk assessment review. Approaches such as lowering the water activity of a formula, using airless packaging, etc., will help but the bottom line is: the formulating chemist should be able to use every resource available to deliver a safe and efficacious formula to the consumer – without being restricted by an ingredient listing that has no relevance to today’s marketplace.
By recognizing multifunctionals for their preservative contribution to a formulation, it encourages suppliers to continue the search for new antimicrobials, it increases the portfolio of ingredients that a manufacturer can use to ensure preservative efficacy of their formulations, and it helps to reduce the risk of microbial contamination of products out in the marketplace.
Read this article and more in the September 2023 digital magazine.










